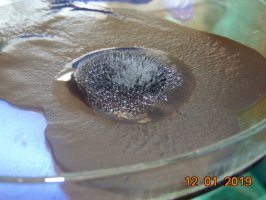

- W dniu 12 stycznia 2019 r. odbyła się kolejna edycja akcji "Studiuj w UMB" Tym razem odwiedzili nas uczniowie z XIV LO w Białymstoku i z I LO w Białymstoku.
Młodzież uczestniczyła w warsztatach naukowych prowadzonych przez pracowników poniższych Zakładów:
- Zakład Chemii Fizycznej pn: "Elektryczność i magnetyzm w otaczająctm nas świecie-zadziwiające właściwości cieczy, owoców i metali."
- Zakład Biochemii Farmaceutycznej pn: "Izolacja DNA z materiału biologicznego"
- Samodzielna Pracownia Biotechnologii pn: "Świat mydeł"
- Zakład Immunologii pn: "Życie i śmierć komórek w obrazie mikroskopowym"
- Zakład Laboratoryjnej Diagnostyki Pediatrycznej pn: "Odmienności diagnostyki laboratoryjnej u dzieci i osób dorosłych"
- W dniu 11 lutego 2019 r.
1.uczniowie z Liceum Ogólnokształcącego w Wydminach brali udział w warsztatach naukowych prowadzonych przez pracowników poniższych Zakładów:
- Zakład Farmacji Stosowanej "Jak zrobić żelki i tabletki i udzielić porad pacjentowi w aptece"
- Zakład Chemii Leków "Magia komórki w praktyce czyli droga z laboratorium do apteki"
- Samodzielna Pracownia Kosmetologii "Fizyka w Gabinecie kosmetycznym"
2. uczniowie z III Liceum Ogólnokształcącego w Białymstoku na warsztatach naukowych "Pachnące Laboratorium" w Zakładzie Farmakognozji.
- W dniu 12 lutego 2019 r. uczniowie z Akademickiego Medycznego Liceum Ogólnokształcącego w Białymstoku uczestniczyli w warsztatach prowadzonych przez pracowników Zakładu Chemii Fizycznej pn."Elektryczność i magnetyzm w otaczającym nas świecie-zadziwiające właściwości cieczy, owoców i metali" i Zakładzie Fizjologii i Patofizjologii Doświadczalnej "Fizjologiczne podstawy zdrowego życia"
- W dniu 16 marca 2019 r. w kolejnej edycji akcji "Studiuj w UMB" brali udział uczniowie z II Liceum Ogólnokształcącego w Białegostoku. Młodzież uczestniczyła w warsztatach naukowych prowadzonych przez pracowników poniższych Zakladów:
- Zakład Histologii i Cytofizjologii "Komórka jako element maszynerii organizmu ludzkiego"
- Zakład Chemii Organicznej "Podstawowe techniki laboratoryjne stosowane w chemii organicznej"
- Zakład Syntezy i Technologii Środków Leczniczych "Razem czy osobno-rozdział mieszanin nie jest trudny"
- W dniu 25 marca br. ponownie na Naszym Wydziale w Zakładzie Farmakognozji gościliśmy uczniów z III Liceum Ogólnokształcącego im. K.K. Baczyńskiego w Białymstoku. Tym razem tematem przewodnim warsztatów była "Analiza fitochemiczna"
- W dniu 12 kwietnia 2019 r. uczniowie z Akademickiego Medycznego Liceum Ogólnokształcącego w Białymstoku uczestniczyli w warsztatach naukowych prowadzonych przez pracowników Zakładu Analizy i Bioanalizy Leków pn. "Czego nie wiesz o lekach? Bezpieczeństwo popularnych preparatów na przykładzie hodowli komórkowych" oraz przez Zakładu Analizy Instrumentalnej pn: "Chemia praktyczna"
- W dniu 25 kwietnia 2019 r. uczniowie ze Społecznej Szkoły Podstawowej nr 2 w Białymstoku gościli w Zakladzie Histologii i Cytofizjologii oraz Zakładzie Chemii Leków. Dowiedzieli się wielu interesuących rzeczy na temat komórki.
- W dniu 17 maja 2019 r. uczniowie z Akademickiego Medycznego Liceum Ogólnokształcącego w Białymstoku gościli na Wydziale Farmaceutycznym uczestnicząc w warsztatach naukowych prowadzonych przez pracowników Zakładu Analizy i Bioanalizy Leków pn. "Czego nie wiesz o lekach? Bezpieczeństwo popularnych preparatów na przykładzie hodowli komórkowych" oraz przez pracowników Zakładu Analizy Instrumentalnej pn: "Chemia praktyczna".
- W dniu 22 maja 2019 r. uczniowie klasy VIII ze Społecznej Szkoły Podstawowej nr 2 w Białymstoku gościli w Zakladzie Histologii i Cytofizjologii oraz Zakładzie Chemii Leków.
- W dniu 6 czerwca 2019 uczniowie z Liceum Ogólnokształcącego w Siedlcach brali udział w warsztatach naukowych prowadzonych przez pracowników Zakładu Toksykologii i Zakładu Farmakodynamiki.
- W dniach 25-27 czerwca br uczennice z III LO w Białymstoku brały udział w zajęciach pn. " Naukowe wakacje na UMB" w ramach Szkoły Letniej organizowanej przez Przyrodniczy Uniwersytet Młodzieżowy . Zajęcia prowadzili pracownicy z Zakładu Biologii, ZAkładu Farmakognozji, Zakładu Fizjologii i Patofizjologii Doświadczalnej.
- W dniu 16 listopada br. w kolejnej edycji akcji "Studiuj w UMB" uczestniczyli uczniowie z klas pierwszych z I Liceum Ogólnokształcącego im. A. Mickiewicza w Białymstoku. Młodzież miala okazję uczestniczyć w spotkaniu z Prodziekanem Wydziału Farmaceutycznego ds. Rozwoju dr hab. Katarzyną Socha oraz przedstawicielami Studentów. Młodziez brała też udział w warsztatach prowadzonych przez poniższe Zakłady:
- Zakład Farmacji Stosowanej "Jak zrobić tabletki i żelki oraz udzielić porad pacjentowi w aptece ?"
- Zaklad Diagnostyki Biochemicznej, Zakład Diagnostyki Hematologicznej, Zakład Diagnostyki Klinicznej "Sprawdź czy choroba nie weszłą Ci w krew"
- Zakład Analizy I Bioanalizy Leków "Chemia praktyczna"
- Zakład Toksykologii "Czy powszechnie stosowane leki przeciwbólowe i przeciwgorączkowe są bezpieczne ?"
- Zakład Biotechnologii "Świat mydeł"
- W dniach 20-21 listopada br. gościliśmy uczniów z I Liceum Ogólnokształcącego im. B.Prusa w Siedlcach. Młodzież brała udział w warsztatach prowadzonych przez pracowników: Zakładu Toksykologi " Zagrożenia wynikające z zażywania leków przeciwbólowych i przeciwgorączkowych", Zakładu Farmakognozji "Pachnące laboratorium" Zakładu Analizy i Bioanalizy Leków " Chemia i praktyczna " i " Czego nie wiesz o lekach? Bezpieczeństwo popularnych preparatów na przykładzie hodowli komórkowych", - Zakładu Bromatologii "Wykrywanie zafałszowań w żywności".
- W dniu 26 listopada br uczniowie z II Liceum Ogólnokształacącego w Augustowie brali udział w warsztatach naukowych prowadzonych przez pracowników poniższych Zakładów:
- Zakład Fizjologii i patofizjologii Doświadczalnej:" Choroby układu krążenia jako przykład chorób cywilizacyjnych"
- Zakład Histologii i Cytofizjologii "Komórka jako element maszynerii organizmu ludzkiego"